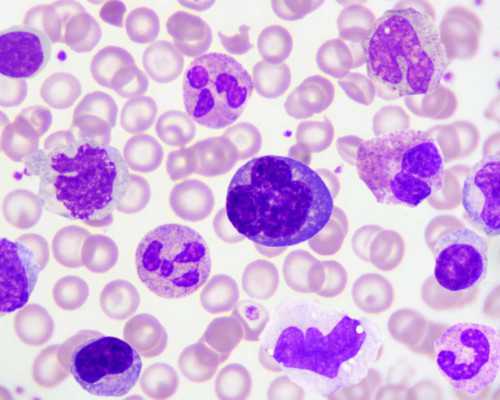
沈阳市妇婴做试管怎么样，沈阳市妇婴医院试管是不是一对一的？

沈阳市妇婴医院目前以围产医学科、妇科、生殖医学科为三大支柱科室,其中生殖中心在反复种植失败、反复流产等特殊疑难病例方面积累了丰富的临床经验,不孕不育患者可以到该院做试管婴儿,但流程相对较多,分析如下:
1、前期检查:医院需要夫妻双方都进行检查,丈夫的检查时间安排在禁欲3-7天,妻子的初检时间可在月经第2-4天或月经第10天左右;。
2、促排卵:确定适合试管婴儿后,制定可控超促排卵方案;监测卵泡,评估卵巢刺激效果,决定取卵时间;
3、取卵:取卵方法一般选择在注射镇痛剂或静脉麻醉下,在阴道B超引导下,将取卵针穿过阴道穹窿,直接将卵巢吸入卵子,并立即在显微镜下将卵子转移到盛有胚胎培养液的培养皿中,置于37摄氏度的培养箱中培养;
4. 取精:精子在取卵当天取精。取精前洗净双手,采用手淫法保留精液,注意避免接触无菌、无毒的取精杯内口,确保取精完整;
5、体外受精: 取卵4-5小时后,将处理好的精子和卵子放入同一培养皿中,共同培养18小时,即可在显微镜下观察受精情况。如果 精子 的质量太差,无法自然受精,则必须用显微注射法强制受精;
6. 胚胎移植: 胚胎移植的数量取决于患者的年龄、既往妊娠情况和胚胎质量,多余的胚胎可以冷冻保存。胚胎移植无需麻醉。目前,胚胎移植多在受精后 2-3 天进行;
7、补充激素: 胚胎移植后给予激素补充,目前多以注射黄体酮为主,支持黄体保胎;
8、确认妊娠:胚胎移植后第14天检测晨尿和血HCG确定是否妊娠,妊娠28天后B超检查胎儿数量和胚胎着床部位。
一般来说,沈阳市妇幼医院 试管婴儿的做法比较复杂,有很多流程,分别为术前检查、控超排卵、取卵、体外受精、胚胎移植、移植后黄体支持等。此外,患者在准备做试管婴儿前,建议双方戒烟、戒酒、戒槟榔,保持充足的睡眠和良好的心情,养成良好的生活习惯。另外,如果生殖系统有炎症,需要积极治疗,以免导致试管成功率降低。